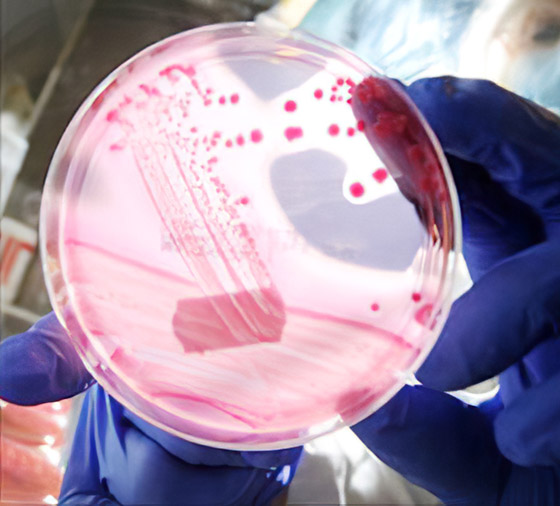
ماذا نعرف عن فيروس ماربورغ الجديد الفتاك؟ تسجيل أول وفاة في غينيا صورة رقم 8

ماذا نعرف عن فيروس ماربورغ الجديد الفتاك؟ تسجيل أول وفاة في غينيا
قالت منظمة الصحة العالمية، أمس الاثنين، إن السلطات الصحية في غينيا سجلت وفاة بفيروس "ماربورغ"، في حالة هي الأولى التي يُسجل فيها ذلك المرض الفتاك في غربي أفريقيا. وكان هناك 12 تفشيا كبيرا لفيروس "ماربورغ" منذ عام 1967 معظمها في جنوبي وشرقي القارة الأفريقية. وقالت منظمة الصحة العالمية إن معدلات الوفاة في الإصابة بفيروس "ماربورغ" تتراوح بين 24 و88 % في موجات التفشي السابقة، موضحة أن النسبة تعتمد على سلالة الفيروس وأسلوب مواجهة الحالات.
ما هو فيروس ماربورغ؟
ينتمي فيروس "ماربورغ" إلى نفس عائلة إيبولا، وقد تفشى في السابق في أماكن أخرى عبر أفريقيا بأنغولا والكونغو وكينيا وجنوب أفريقيا وأوغندا. ويبدأ تفشي فيروس ماربورغ عندما ينقل حيوان مصاب، مثل القرد أو خفاش الفاكهة، الفيروس إلى الإنسان، الذي ينقله بدوره إلى إنسان آخر عن طريق ملامسة سوائل جسم الشخص المصاب.

ووفقا لمنظمة الصحة العالمية فإن عدوى فيروس "ماربورغ" تحدث من خلال ملامسة إفرازات الجسم المصاب وأنسجته، مشيرة إلى أنه عبارة عن حمى نزفية شديدة العدوى شبيهة بفيروس إيبولا. وتشمل أعراض الإصابة بالفيروس الفتاك هذا، الصداع وتقيؤ الدم وآلام العضلات، بالإضافة إلى ارتفاع درجة حرارة المصاب بالفيروس.

وينزف بعض المرضى في وقت لاحق من خلال فتحات الجسم مثل العينين والأذنين. ولا يوجد دواء أو لقاح معتمد ضد فيروس ماربورغ، لكن معالجة الجفاف والرعاية الداعمة الأخرى يمكن أن تحسن فرص المريض في البقاء على قيد الحياة. يشار إلى أنه معدلات الوفاة للمصابين بالفيروس كانت عالية ووصلت إلى 88 % في حالات التفشي السابقة، إلا أن منظمة الصحة العالمية قالت إن العدد يختلف، بناء على السلالة وكيفية التعامل مع حالات الإصابة.

للتواصل معنا
للتواصل معنا 